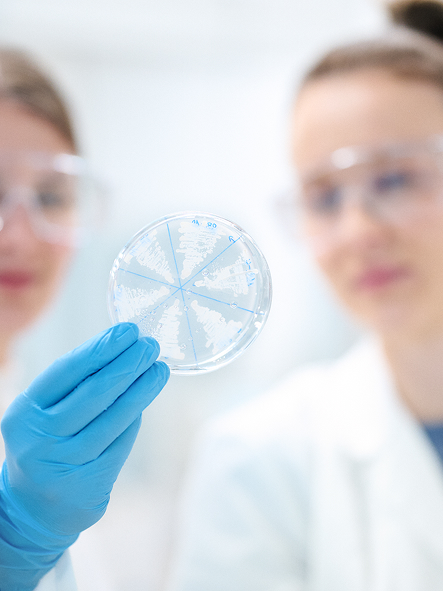

To the next 25 years of achievements
For 25 years, Basilea has been at the forefront of creating anti-infective medicines, shaping the future of infectious disease treatment, and saving the lives of patients worldwide. Our journey has been guided by scientific excellence, a commitment to innovation, and an unwavering focus on addressing serious and life-threatening conditions. As we reflect on a quarter-century of achievements, we take pride in the progress we have made, and the opportunities that lie ahead.
This milestone is also a celebration of collaboration. Through strong and trusted partnerships with companies such as Advanz Pharma, Asahi Kasei Pharma, Astellas Pharma, Avir Pharma, CR Gosun, Hikma Pharmaceuticals, Innoviva Specialty Therapeutics, JSC Lancet, Knight Therapeutics, Pfizer, and Unimedic Pharma, our medicines now reach patients in over 75 countries. Together, we continue to expand access, advance innovation, and make a tangible difference for patients around the globe.
Together we make a difference
For 25 years, Basilea has put patients at the very heart of everything we do. We are dedicated to improving the lives of people facing serious infectious diseases, ensuring that our medicines have a lasting benefit and provide hope. Every therapy we bring to market reflects our commitment to addressing urgent medical needs with expertise, care, and persistence. As we celebrate our anniversary, we remain inspired by the patients and healthcare professionals we serve and the difference we want to make in their lives every day.
Creating anti-infective opportunities
Innovative strength shapes who we are and determines how we approach challenges in the field of infectious diseases. Over the past quarter-century, Basilea has developed new therapies and advanced treatments that address previously unmet medical needs. Our ongoing commitment to developing high-quality solutions and our forward-looking approach help us to further develop targeted therapies and provide patients with reliable new treatment options. With each drug that is successfully approved and brought to market, we strengthen our position as a committed company and reliable partner in the field of anti-infectives.
Powered by collaborations and partnerships
Our impact is strengthened through collaboration. By partnering with leading pharmaceutical companies, we have expanded the availability of our medicines to more than 75 countries and facilitated access for patients worldwide. These partnerships enable the exchange of expertise, resources, and insights, allowing us to tackle complex challenges together. As we look to the future, our collaborative spirit will continue to drive growth, innovation, and meaningful outcomes for patients, demonstrating the power of working together to save lives.